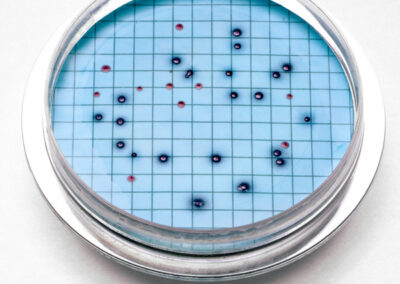

Reactivos y estandares
HACH
Microbiologia
Test Kit
Test Strips
Estándares
Aliados
HACH
Productos Hach
Personalice los medios o diluya las muestras para satisfacer necesidades específicas de muestras. Hach ofrece frascos estériles para muestras, agua de dilución, indicadores por colores, tampones, ácidos, reactivos, tubos de cultivo, estándares y polvos para usarlos en procesos de análisis. Hay productos disponibles para aguas recreativas, aguas residuales, agua potable y otros procesos y matrices de muestras. Todos los reactivos se someten a una inspección rigurosa y un proceso de control de calidad antes de salir de la fábrica.
Contamos con certificados que acreditan la calidad y procedencia de nuestros reactivos, para apoyar sus procesos de auditorias y acreditaciones.
Microbiología
Test Kit
Los test kit de agua para análisis en campo, laboratorio y como acción rápida para la detección de aguas contaminadas en una gran variedad de condiciones ambientales.
Estos kits fáciles de usar con una formación mínima, portátiles y con resultados fiables son la opción ideal para la medición de parámetros en aguas desde la A a la Z.
Los discos de color usan un método de comparación visual (comparación de colores) para determinar la concentración. Solo tiene que agregar reactivos a la muestra y girar la rueda hasta que la muestra coincida con un color de referencia. La concentración se muestra en una ventana.
Todos los test kit de disco de color de Hach incluyen los aparatos, reactivos e instrucciones, todo ello en un resistente maletín de transporte. Los parámetros disponibles son cloro, pH, hierro, sílice, nitrógeno, etc.
Los kits monoparamétricos ofrecen simplicidad al realizar análisis de un parámetro específico en el laboratorio o sobre el terreno. Las distintas plataformas ofrecen un amplio rango de funciones, que abarcan desde valoración por recuento de gotas, de bajo coste y fácil de usar, a los kits con valorador digital de gran exactitud. Cada test kit de Hach incluye todo lo necesario para iniciar los análisis, desde los instrumentos necesarios a un completo set de reactivos, todo en un robusto maletín de transporte de Hach.
Test strips
Aliados
MOLLABS
Desde Mol Labs ofrecemos soluciones listas para el uso, que aportan tiempo y facilidad a la realización del análisis:
1. Ahorran tiempo de analistas en la preparación
2. Facilitan los cálculos y reducen este tipo de error, tan frecuente
3. Permiten identificar rapidamente valores extraños en la medición (outliers)
4. Reducen el almacenamiento de sustancias peligrosas en el laboratorio.
5. Son la mejor opción para preparaciones complicadas o de varios componentes.
6. Preparación de soluciones según su necesidad.
PANREAC
La División ITW Reagents está integrada por las empresas Panreac Química SLU (España), AppliChem GmbH (Alemania) y ITW Reagents, S.R.L. (Italia) con el objetivo de reunir la experiencia y los conocimientos técnicos de tres empresas experimentadas.
La División ofrece los productos más innovadores y de mejor calidad para la investigación química, biológica, farmacéutica y médica, así como para uso industrial.
MERCK
Reactivos con especificaciones y acreditaciones que cumplen con estándares globales, documentación de calidad para acreditación y auditorías.